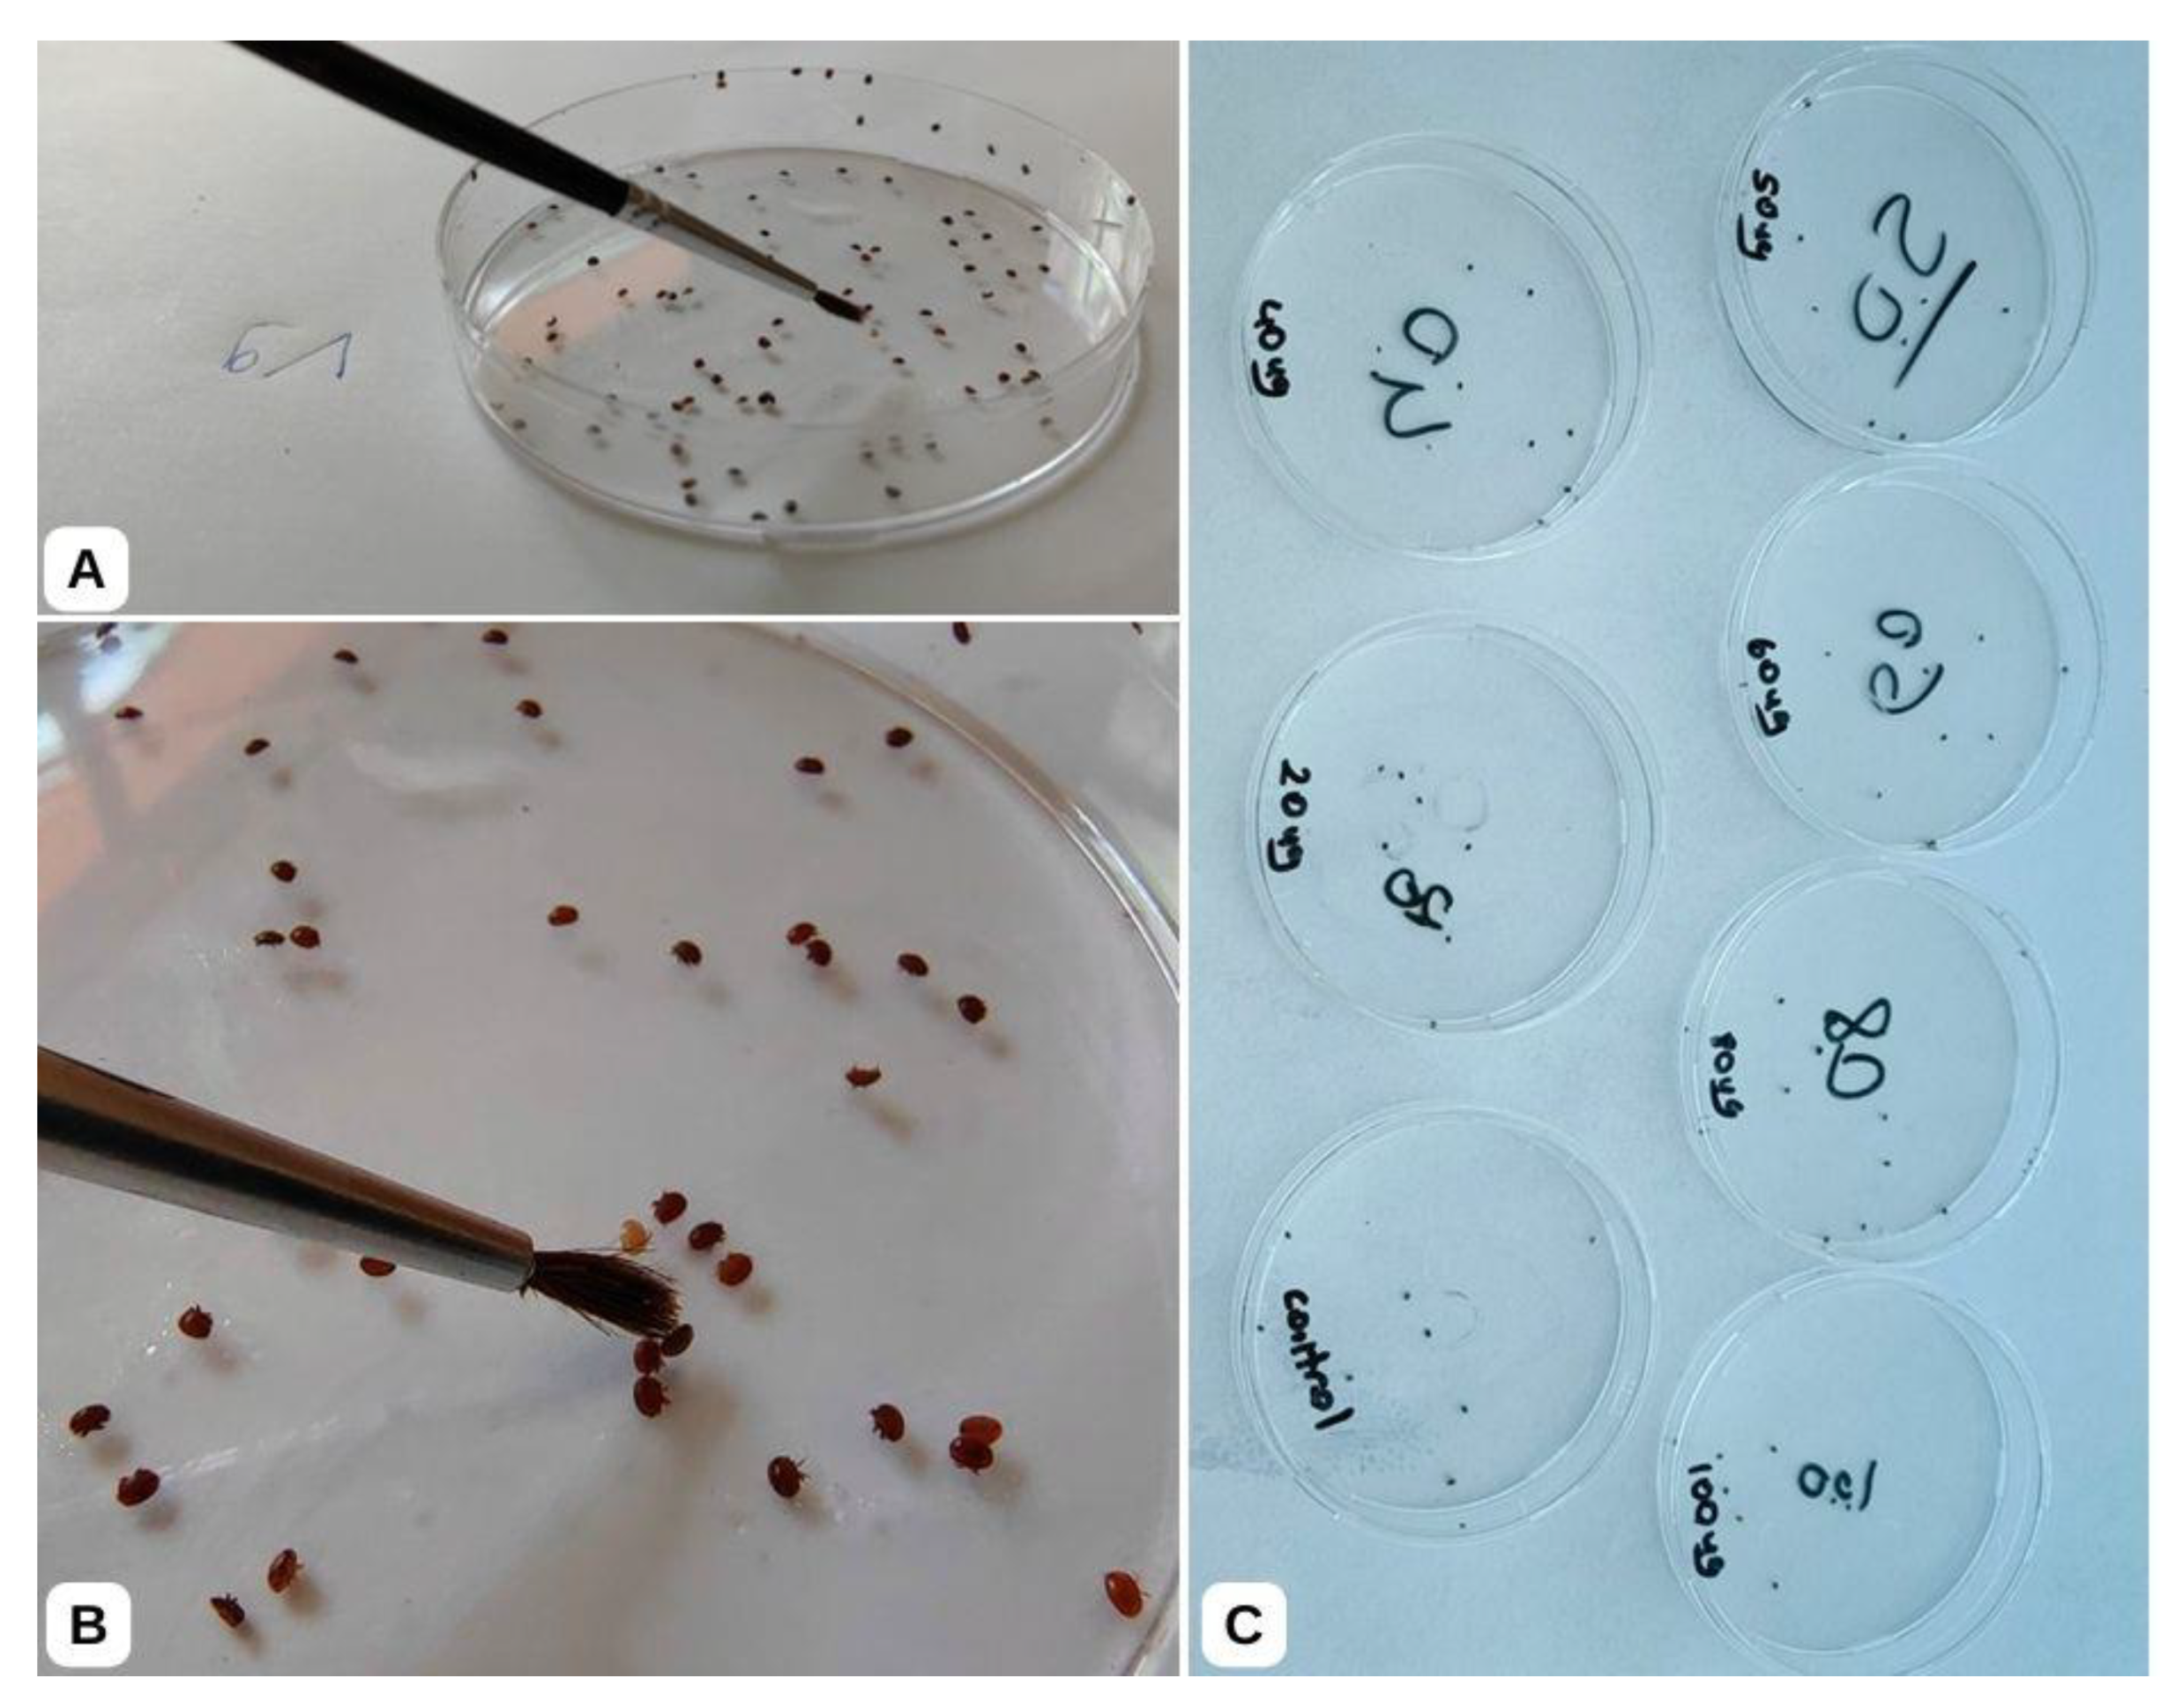
Insects 16 00548 g002

Simple Summary
Varroa destructor (varroa) is a major parasitic threat causing significant colony losses around the world. While flumethrin remains a widely used acaricide, its efficacy has declined substantially due to evolving pesticide resistance, exacerbating colony and yield losses. This study evaluates flumethrin resistance through LD50 analysis and mutational profiling of the voltage-gated sodium channel (VGSC) L925 locus. Our findings reveal dramatically elevated LD50 values compared to previous studies, indicating widespread resistance. Notably, 95% of the population carried homozygous resistant alleles (L925I/M/V), underscoring the urgent need for alternative control strategies.
Abstract
Beekeepers use a variety of methods to control Varroa destructor (varroa). Chemical control relies heavily on flumethrin, amitraz, coumaphos, and tau-fluvalinate products. However, increasing colony losses in recent years have been linked to the development of resistance in varroa mites to these insecticides. Varroa mites develop mutations in the voltage-gated sodium channel (VGSC) that confer resistance to pyrethroids such as flumethrin. Specifically, researchers have identified substitutions of the leucine amino acid at VGSC L925 with isoleucine, methionine, or valine. This study investigated phenotypic and genotypic resistance to flumethrin in varroa populations in Muğla, Türkiye. LD50 values (lethal dose for 50% mortality) were quantified, and PCR and sequencing were used to analyze the VGSC L925 gene region. The PCR results confirmed mutations in the target gene region in all samples. Sequencing revealed that 95% of the population carried homozygous resistant alleles, while 5% were heterozygous. At the VGSC L925 locus, leucine was replaced by isoleucine (91%), methionine (6%), and valine (3%). Phenotypic assays showed an average LD50 value of 49.1 µg (range: 31–61.8 µg). Comparison of LD50 between resistant and susceptible populations was not possible because no susceptible individuals were identified. Despite the resistance, mortality increased with escalating doses, suggesting that current protocols may be temporarily mitigating infestations. However, urgent dose adjustments and alternative control strategies are critical to prevent imminent colony collapse.
1. Introduction
Varroa destructor is one of the most significant threats to honeybee health due to the direct damage it inflicts, the physiological stress it induces, and its role as a vector for secondary pathogens [1]. Therefore, effective varroa management is critical to sustaining global apiculture [1]. Beekeepers employ diverse strategies to control varroa mites, including physical, biological, chemical, and genetic methods. Chemical interventions, such as synthetic acaricides (e.g., amitraz, coumaphos, tau-fluvalinate, and flumethrin), organic acids, and essential oils, remain central to these efforts [2]. The choice of treatment depends on environmental and hive-specific factors, including temperature, humidity, brood presence, and proximity to foraging seasons [2]. However, physical and biological methods often prove insufficient, necessitating integration with chemical controls to achieve adequate mite suppression [3].
Among synthetic acaricides, pyrethroids like flumethrin are widely used due to their neurotoxic mechanism: they disrupt insect nerve function by prolonging sodium channel activation during neural signalling, leading to spastic paralysis and death [4,5]. For example, commercial plastic strips impregnated with 3.6 mg of flumethrin are applied in hives to eliminate varroa via contact exposure [4,5]. Despite their efficacy, overreliance on pyrethroids has driven the evolution of resistance in varroa populations, resulting in treatment failures and escalating acaricide residues from higher dosage applications [6,7,8]. Some studies clearly show that the effectiveness of pyrethroids to varroa is reduced [9,10]. Flumethrin resistance was first documented in Italy and has since spread across Europe (e.g., Slovenia, Switzerland, Poland, France, Belgium, England, Austria) and beyond, with confirmed cases in Mexico and Uruguay [6,7,8]. Phenotypic resistance is increasingly evident in elevated LD50 (median lethal dose) values reported globally, though no prior studies have quantified flumethrin-specific LD50 levels in Türkiye [4,11,12,13].
In Türkiye, molecular evidence of resistance has emerged in studies which detected mutations in the voltage-gated sodium channel (VGSC) gene (L925 locus) linked to pyrethroid resistance in 69–75% of varroa samples from some regions in Türkiye [14,15,16]. However, in Turkish varroa populations, phenotypic resistance levels (e.g., LD50) and their correlation with genotypic mutations remain uncharacterized.
This study investigates both genotypic and phenotypic resistance to flumethrin in Varroa destructor from Muğla, a region pivotal to Turkish beekeeping due to its high colony density, pine honey production, and role as a wintering hub. We quantified acute LD50 values to assess phenotypic resistance and analyzed the VGSC L925 locus for mutations associated with pyrethroid resistance. Our findings may inform adaptive management strategies to mitigate resistance-driven colony losses.
2. Materials and Methods
2.1. Collection of Varroa Samples
The varroa mites used in this study were collected from 27 apiaries in the districts of Milas, Dalaman, Menteşe, Köyceğiz, and Ula, which are in the Muğla region of Türkiye, from May to October 2021 (Table 1). Two collection methods were used in the preliminary trials: collection from brood cells and powdered sugar on adult bees. The powdered sugar method was selected due to higher mite yields (Figure 1). Beekeepers were recruited through the Muğla Beekeepers Association, Provincial and District Directorates of Agriculture and Forestry. In preliminary interviews with the beekeepers, apiaries that used flumethrin at least once a year were preferred. A3 paper was placed on the hive floor or pollen drawer, and powdered sugar was sprayed between the frames to collect varroa from the hives.
Table 1.
LD50 results of varroa samples collected from apiaries and mortality by dose.
Figure 1.
Collection of live varroa samples from the beehives. (A) Laying A3 paper under the frames; (B) applying powdered sugar between the frames on the honeybees; (C) collecting varroa falling on the paper; (D) sieving the powdered sugar with a sieve to clean the varroa.
The aim was to collect 100 to 150 live varroa from each apiary. The collection paper on the hive floor was carefully removed 5 min after applying the powdered sugar. A paintbrush was used to separate powdered sugar residues from the fallen varroa mites (Figure 1). To ensure that the collected mites had survived the collection and cleaning procedures, they were held in petri dishes (an average of 100–150 varroa per apiaries) with a small paper towel inside. Only the varroa mites that remained alive after 3 h post-collection procedures were used in the LD50 test (Figure 2). The varroa mites that moved after the paintbrush was touched and attached to the paintbrush were considered alive and separated for the LD50 study. After completing the LD50 tests, the varroa mites were stored at −20 °C for further analyses of flumethrin resistance mutations.
Figure 2.
The LD50 analyses of varroa mite samples were performed in petri dishes. (A) The varroa mites cleaned before were removed with a paintbrush into a clean petri dish; (B) varroa mites were kept for 2 h and then checked for viability with a paintbrush touch; (C) active varroa mites were transferred to petri dishes loaded beforehand with different concentrations of flumethrin for LD50 tests.
Varroa mites were exposed to flumethrin in a single Petri dish per dose (no biological replicates). Ten mites were tested per dose, and mortality was recorded. The term “Average Mortality” in Table 1 refers to pooled data across three apiaries, not technical replicates.
2.2. Acute LD50 Analysis and Determination of Phenotypic Resistance
The lethal dose (LD50) study was conducted by modifying the method of Maggi et al., 2008 [12]. Varroa samples were collected from 3 different apiaries, and susceptibility ranges were determined by preliminary testing. Bayticol® (flumethrin 1% Bayer-Germany) was used to prepare different concentrations of flumethrin (2 mL). Dilutions of flumethrin were made using hexane. The dilutions of flumethrin were loaded in 13 petri dishes with 10,000 µg, 7500 µg, 5000 µg, 3600 µg (amount in the original preparation), 2500 µg, 1000 µg, 500 µg, 250 µg, 100 µg, 50 µg, 25 µg, and 10 µg flumethrin and only hexane as a control. To ensure homogeneous distribution of flumethrin on the petri dishes, a further 2 mL of hexane was added to each petri dish after application, spread well on the bottom, and then dried at room temperature. In preliminary studies, the average mortality ranged from 50 µg to 25 µg, and all varroa died at 100 µg. As a result of the preliminary experiment, petri dishes were prepared by loading 0, 10, 20, 40, 50, 60, 60, 80, and 100 µg of flumethrin and a control (hexane). After assessing varroa mite viability, 8–13 varroa mites were placed in a single Petri dish per dose (no biological replicates), exposed to flumethrin for two hours, and then reassessed for viability by touching a paintbrush (Figure 2). The number of varroa placed in the petri dishes decreased to 8 in locations where live varroa mites were low and increased up to 13 in locations where live varroa mites were high. A separate paintbrush was utilized for each dosage to prevent contamination in the control. Dead and live varroa mites in petri dishes were recorded for LD50 analysis. The averages were obtained by optimizing the mortality according to 10 varroa mites, as shown in Table 1. The calculated LD50 value was written over this optimized value.
Acute median lethal dose (LD50) analysis was conducted using the Karber–Behrens method, a simplified approach providing a rough estimate without confidence intervals or statistical modelling of dose–response curves with the formula LD50 = LD100 − [Σ(ab)/n]. LD100 is the dose that caused 100% mortality in the experiment, n is the number of animals in each group, a is the difference between two consecutive doses, and b is the arithmetic means of the deaths caused by two consecutive doses. While logistic regression would offer greater rigor, resource constraints precluded its use. These limitations should be considered when interpreting LD50 reliability.
Finally, the varroa mites were stored in Eppendorf tubes at −20 °C for further analyses of flumethrin resistance mutations.
2.3. DNA Isolation from Varroa Samples
High-quality DNA could not be isolated from 5 apiaries (V23–V27) out of the 27 sampled, so molecular analyses proceeded with 22 apiaries. First, varroa samples were sorted by location and labelled (V1–V22). For each location, five mites were pooled into a single tube, and DNA was isolated using a commercial kit (GeneAll Exgene Kit, Animal Tissue protocol, GeneAll Biotechnology, Seoul, South Korea).
Due to the tough exoskeleton of varroa mites, the samples were mechanically disrupted using glass beads of varying sizes and lysis buffer, followed by vigorous vortexing. Next, 250 µL of lysis buffer (BL) was added, and the samples were vortexed for 5 min, incubated at 70 °C for 10 min, vortexed again, and flash-frozen at −80 °C for 10 min. This freeze–thaw–vortex cycle was repeated three times, as per the kit protocol. DNA was eluted twice with 40 µL of AE buffer, quantified via Nanodrop spectrophotometry, and visualized on 1% agarose gel for quality assessment. Isolated DNA was stored at −20 °C.
2.4. Amplification of the VGSC Gene Region by PCR Using Appropriate Primers
Due to limited DNA quantities, 5 µL of each sample was used for preliminary PCR screening with RAPD primers (OPB-05) to confirm amplifiable DNA. The reaction mixture included template DNA, 10 µM OPB-05 primer, 200 µM dNTP mix, 1 U Taq DNA polymerase, 1× PCR buffer, 1.5 mM MgCl2, and nuclease-free water. Successful amplification with RAPD primers confirmed DNA integrity. Subsequently, the voltage-gated sodium channel (VGSC) gene region was targeted using primers 1273iF (5′-AAGCCGCCATTGTTACCAGA-3′) and 1973iR (5′-GCTGTTGTTACCGTGGAGCA-3′), validated by Millán-Leiva et al. (2018) [17]. Reactions were performed in triplicate under identical conditions: initial denaturation: 94 °C for 2 min, 35 cycles of denaturation: 94 °C for 30 s, annealing: 51 °C for 30 s, extension: 72 °C for 60 s, and lastly, additional final extension: 72 °C for 10 min.
PCR products were resolved on 0.8% agarose gels, stained with ethidium bromide, and visualized under UV light.
2.5. RFLP Analysis of the PCR Products
Restriction Fragment Length Polymorphism (RFLP) analysis was performed on the amplified PCR products, following the protocol of Millan-Leiva et al. (2018) [17]. Briefly, PCR products were digested with the SacI restriction enzyme (Thermo Fisher Scientific, Waltham, MA, USA). The resulting restriction fragments were then separated by electrophoresis on a 2% TBE agarose gel. Following electrophoresis, the gel was stained, visualized under UV light, and the banding patterns were documented using a gel imaging system.
2.6. DNA Sequencing of Some of the VGSC PCR Products by Sanger and Bioinformatics Analysis
Based on RFLP results of the varroa samples from 22 locations, 12 samples (V1, V2, V4−V10, V20, V22) were selected for Sanger sequencing to confirm the absence of homozygous susceptible (SS) genotypes, verify the SacI restriction enzyme digestion efficiency, and resolve codon-level genotypic ambiguities. This enabled the simultaneous validation of RFLP interpretations and the detection of novel mutations. Chromatograms were analyzed using BioEdit v7.2.6 and MEGA X for base calling, alignment, and phylogenetic analysis, with sequence homology confirmed via BLASTN (NCBI Nucleotide Database, 2024, The National Center for Biotechnology Information, Bethesda, MD, USA).
3. Results
The mortality of the varroa samples by dose is presented in Table 1. No mortality was observed in the control group. LD50 values ranged from 31 µg (lowest) to 61.8 µg (highest), averaging 49.13 µg, with most values clustering between 40 and 50 µg (Table 1).
DNA isolation from 22 varroa samples (collected from 27 beekeepers) was performed following the protocol. Agarose gel electrophoresis and Nanodrop measurements confirmed successful isolation. PCR amplification of the VGSC gene region was achieved for all 22 locations.
3.1. RFLP Analysis of PCR Products
The PCR products were analyzed via Restriction Fragment Length Polymorphism (RFLP) using the SacI restriction endonuclease enzyme. Digested fragments were separated on 2% TBE agarose gel (Figure 3). No bands corresponding to susceptible (SS) genotypes (438 bp and 263 bp) were observed, confirming widespread resistance. Allele frequencies were quantified using ImageJ and visual inspection [18], with the results categorized by genotype (Table 2).
Figure 3.
Agarose gel image of varroa PCR products cut with SacI restriction enzyme for RFLP analysis.
Table 2.
Evaluation of VGSC profiles according to RFLP results and allele probabilities of varroa samples.
RFLP band densities were examined to detect allele frequencies in the mites using the approach of Stara et al. (2019) using the ImageJ software (version 1.54h, The National Center for Biotechnology Information, Bethesda, MD, USA) and visual observation [18]. When interpreting the PCR-RFLP bands after SacI enzyme cleavage, only two fragments (bands) of 438 and 263 bp should have been observed due to the presence of the codon encoding the amino acid leucine (CTG) in the drug-sensitive homozygous (SS) mites. This was not detected in the samples when the gel images were analyzed. According to the RFLP results of the samples, the VGSC (voltage-gated sodium channel) profiles were evaluated and separated according to allele groups (Table 2).
3.2. Bioinformatics Analysis of VGSC PCR Products
Sanger sequencing chromatograms from 12 locations (V1, V2, V4–V10, V20, V22) were analyzed using the BioEdit software version 7.2.5 (see Mitton et al., 2021) [19]. Sequence results were analyzed using Bioedit, MEGA X, and BlastN to identify mutations (alleles) [19]. DNA isolation and PCR were performed on five mites per location. Genotypes were determined by integrating PCR-RFLP band intensities, as described by Stara et al., 2019 [18], and sequence chromatogram profiles (as reported by Mitton et al., 2021) [19]. The resulting genotypes of 110 Varroa mites are summarized in Table 3.
Table 3.
Determination of alleles of varroa (V) samples according to RFLP and sequence results.
Sequence analysis confirmed the Leu (CTG) → Ile (ATA) mutation in V1 (V1a–V1e), V2 (V2a–V2e), V4 (V4a–V4e), V5 (V5a–V5e), V6 (V6a–V6e), V7 (V7a–V7e), and V22 (V22a–V22e) (Figure 4, Figures S1–S5 and S9). The combined RFLP and sequencing results classified all five individuals per sample as homozygous resistant (Ile/Ile) (Table 3).
Figure 4.
Bioinformatic analysis of the sequence result of sample V6.
Sequence analysis of the V8 sample revealed the Leu (CTG) → Ile (ATA) mutation (Figure 5). When the genotype was interpreted according to the RLFP and sequence results, in general, 70% of the alleles were resistant alleles (Ile/Ile), and 30% were GTG (Val) alleles (Table 3). Sequence analysis of the V9 sample clearly showed the Leu (CTG) → Ile (ATA) mutation (Figure S6). When the genotype was interpreted according to the RLFP and sequence results, in general, 70% of the alleles were resistant alleles (Ile/Ile), and 30% were ATG (Met) alleles (Table 3).
Figure 5.
Bioinformatic analysis of the sequence result of sample V8.
Analysis of the sequence of the V10 and V20 samples showed the Leu (CTG) → Ile (ATA) mutation (Figures S7 and S8). When the genotype was interpreted according to RLFP and sequence results, 70% of the alleles generally contained resistant alleles (Ile/Ile), and 20% contained ATG (Met) alleles. In addition, 10% of the alleles contained the CTG (Leu) S allele (Table 3).
In addition, mutations were detected in different regions of the VGSC, i.e., regions 147: TGTCGA → TGTCAA of the V9 samples (Figure S6); region 149: GTCGAG → GTCAAG of the V5 samples (Figure S4); region 150: TGTCGA → TGTCAA of the V7 and V8 samples (Figure 5 and Figure S5); and region 423: CAGGGA → CGGGGA of the V1 samples (Figure S5). While these mutations are not currently linked to resistance, their functional roles warrant further investigation.
A total of 110 mites were analyzed (22 pooled samples × 5 mites per pool), yielding 220 alleles (diploid genome). RFLP analysis identified RR (homozygous resistant) and SR (heterozygous) genotypes in the pooled samples. Allele frequency analysis revealed 103 resistant (R) alleles encoding isoleucine (Ile, ATA), 7 methionine (Met, ATG), and 3 valine (Val, GTG). RFLP data corroborated 96 R alleles, with 209/220 alleles (95%) classified as resistant. Only 11 susceptible (S) alleles (Leu, CTG) were detected, indicating that the heterozygous pools retained residual susceptibility.
Isoleucine (Ile) predominated among the resistant alleles (91%), followed by methionine (6%) and valine (3%). With S alleles constituting just 5% (11/220) of the population, directional selection will likely drive near-complete fixation of R alleles in subsequent generations. Consequently, 95% of the mites were homozygous resistant (RR), while 5% were heterozygous (SR).
4. Discussion
In the present study, varroa mite samples were exposed to different concentrations of flumethrin acaricide, and acute LD50 values were calculated. However, since all the individuals subjected to molecular analysis were resistant, comparisons of LD50 values between resistant and susceptible populations were unattainable. For meaningful interpretation of LD50 data, baseline susceptibility levels must first be established by characterizing susceptible individuals within the population. Additionally, while three distinct mutations were identified in the gene encoding the voltage-gated sodium channel (VGSC) protein—the target site of flumethrin—the relationship between these mutations and dose-dependent mortality warrants further investigation. Flumethrin is typically introduced to hives via impregnated strips (commonly 3.6 mg), where it translocates into bee fat or tissues. Varroa mites succumb to the acaricide through direct contact or ingestion during bee feeding. The calculated average LD50 of 49.1 µg indicates the dose required to achieve 50% mortality in the tested population. Consistent with findings by Wu et al. (2023), we propose applying varying flumethrin concentrations to honeybees, quantifying residue levels in bee tissues, and correlating these with varroa LD50 thresholds to refine field dosing strategies [20].
Furthermore, the toxicity of these doses to honeybees and their behavioural effects warrant investigation. Previous studies employing similar methodologies reported significantly lower LD50 values: Maggi et al. (2008), in Argentina, documented an LD50 of 0.34 µg, Goodwin et al. (2005), in New Zealand, observed 12 µg, and Mitton et al. (2016), in Uruguay, identified 3.8 µg [4,12,13]. However, a recent study by McGruddy et al. (2024) in New Zealand reported an LD50 of 156 µg—3-fold higher than our findings (49.1 µg) and 26-fold higher than earlier New Zealand data [11,13]. Intriguingly, despite this elevated LD50, no L925V mutations were detected, suggesting that resistance may arise through alternative mechanisms, such as metabolic detoxification or target-site modifications beyond the L925 locus. These trends predict a continued escalation in LD50 values unless resistance management strategies are implemented. If sensitive individuals had been identified in our study, appropriate comments could have been made on the phenotypic resistance of resistant and sensitive individuals according to the L50 level, and the contribution of the change in genotype to the phenotype could have been assessed. Longitudinal monitoring of LD50 levels, as demonstrated in New Zealand, provides a phenotypic framework to track resistance evolution over time. Such data, combined with mutational profiling, could clarify the contribution of specific amino acid substitutions to resistance severity.
Synthetic pyrethroids (e.g., flumethrin, tau-fluvalinate) have been extensively used to control Varroa destructor mites, a major contributor to honeybee colony losses. Resistance in this mite was first reported in the Lombardy region of Italy during the 1990s [21]. Studies have identified three distinct mutations in the gene encoding the voltage-gated sodium channel (VGSC) protein of varroa mites at leucine position 925 (L925) in flumethrin-resistant populations [17], specifically L925V, L925I, and L925M substitutions [17]. To address the need for the rapid detection of these mutations across populations, a PCR-RFLP assay was developed, enabling widespread screening for pyrethroid resistance. Given the limited arsenal of effective acaricides, this molecular approach provides a critical tool for determining pyrethroid resistance status in global varroa management programs. Long-term control strategies now necessitate routine resistance monitoring to inform adaptive mitigation efforts.
These findings confirm that mutations arose at the drug’s target site across the entire population, corroborated by sequence analysis. Of the 85 mites analyzed from 17 locations, RFLP profiling of 5 pooled samples revealed heterozygous (SR) genotypes (bands at 701-, 438-, and 263-bp) alongside putative homozygous resistant (RR) individuals. The absence of homozygous susceptible (SS) genotypes via RFLP necessitated Sanger sequencing for validation. Sequencing unambiguously identified alleles, and heterozygous allele frequencies were quantified through visual inspection and ImageJ analysis, as described by Stara et al. (2019).
Surprisingly, most mites exhibited a resistance profile. Specifically, 95% carried resistant alleles (R; L925V/I/M), while only 5% retained the susceptible allele (S; Leu). Among the resistant alleles, 91% encoded isoleucine (Ile), 3% valine (Val), and 6% methionine (Met). Notably, no homozygous susceptible (SS) mites were detected, and Ile predominated among the resistance-associated mutations. Global studies have identified L925I, L925V, and L925M substitutions in the flumethrin-targeted VGSC gene region [1,4,5,6,8,12,17,22,23,24,25]. These mutations, first reported in Lombardy, Italy, are hypothesized to have disseminated globally [21,26]. In Lombardy, early studies documented 11% homozygous resistant (RR) and 2% heterozygous (SR) individuals for L925I, with susceptible (SS) mites still present [21,26]. In contrast, our study detected near-complete resistance fixation, with 95% RR and 5% SR genotypes and no SS individuals—reflecting a dramatic rise in resistance prevalence.
Similar to our findings, Benito et al. (2018) reported widespread homozygosity and all three mutations in Spain [1]. In the U.S., Millán-Leiva et al. (2021) also linked flumethrin resistance to L925 substitutions [8]. Regional variations exist: Alissandrakis et al. (2017), in Greece, reported higher L925I prevalence (54% RR) [27], while Vlogiannitis et al. (2021), in Belgium, observed L925V-driven resistance (LC50 increased 12.64-fold) [6]. Globally, L925V dominates in Europe [23], whereas L925I and L925M are prominent in Iran [24], Canada [28], and Argentina/Uruguay [19].
In Türkiye, earlier studies detected L925V/I (75% resistance) in Muğla but retained susceptible individuals [16], consistent with national findings of 69% resistance [14,15]. However, a 2021 Turkish study reported 91% resistance [15], aligning with our results. Notably, our study newly identified L925M (6%) in Muğla, a mutation absent in prior regional reports [14,15,16]. Discrepancies in mutation frequencies exist; while L925I dominated here (91%), a 2024 Turkish study found L925I in 21% and L925M in 2.8% of mites [14]. Critically, no Turkish studies—including ours—correlated genotypic resistance with phenotypic LD50 data from susceptible populations, limiting mechanistic insights.
The absence of susceptible (SS) varroa samples precluded a direct comparison of LD50 values between resistant and susceptible populations. Consequently, the phenotypic implications of molecularly confirmed resistance (e.g., clinical efficacy thresholds) remain unclear. Notably, substitutions at the VGSC L925 locus (Leu → Ile/Met/Val) showed no correlation with LD50 variability, suggesting these mutations confer comparable resistance levels regardless of the substituted amino acid. Furthermore, point mutations identified in non-target regions (e.g., positions 423, 147, 149, 150) exhibited no measurable impact on phenotypic resistance, as reflected in the unchanged LD50 values.
5. Conclusions
The findings of this study demonstrate widespread genotypic resistance to flumethrin in Varroa destructor populations, corroborated by elevated LD50 values indicative of phenotypic resistance. The combined evidence suggests that flumethrin applications are likely insufficient for effective varroa control, potentially exacerbating colony losses due to sublethal field concentrations. In response, beekeepers may resort to off-label, high-dose flumethrin use, heightening risks of colony collapse and pesticide contamination in hive products. Furthermore, the near-complete fixation of resistant alleles (95% RR, 5% SR) suggests that remaining susceptibility will rapidly erode, as residual susceptible (S) alleles are under intense selection pressure.
To mitigate resistance-driven colony declines, we recommend phasing out flumethrin in regions with confirmed resistance and adopting integrated pest management (IPM) strategies. In areas where efficacy persists, rotational use with non-pyrethroid acaricides is critical to delay resistance evolution. Despite widespread resistance, dose-dependent mortality was observed, implying potential for optimized dosing regimens. However, urgent research is needed to (1) refine flumethrin application protocols, (2) develop novel control agents, and (3) characterize the functional role of non-target mutations (e.g., positions 423, 147, 149, 150) in resistance mechanisms.
Supplementary Materials
The following supporting information can be downloaded at: https://www.mdpi.com/article/10.3390/insects16060548/s1, Figure S1: Bioinformatic analysis of the sequence result of sample V1, Figure S2: Bioinformatic analysis of the sequence result of sample V2, Figure S3: Bioinformatic analysis of the sequence result of sample V4, Figure S4: Bioinformatic analysis of the sequence result of sample V5, Figure S5: Bioinformatic analysis of the sequence result of sample V7, Figure S6: Bioinformatic analysis of the sequence result of sample V9, Figure S7: Bioinformatic analysis of the sequence result of sample V10, Figure S8: Bioinformatic analysis of the sequence result of sample V20, Figure S9: Bioinformatic analysis of the sequence result of sample V22.
Author Contributions
Writing—original draft, A.S.; methodology, A.S. and B.Ç.; molecular analysis, B.Ç., E.D. and A.B.; data analysis, A.S. and B.Ç.; writing—review and editing, A.S. and B.Ç. All authors have read and agreed to the published version of the manuscript.
Funding
This research was funded by the Scientific Research Project Office of Muğla Sıtkı Koçman University, grant number 16/029.22/136/03/1/2.
Data Availability Statement
The original contributions presented in this study are included in the article/Supplementary Material. Further inquiries can be directed to the corresponding author(s).
Acknowledgments
We would like to thank the Muğla Beekeepers Association for supporting the research.
Conflicts of Interest
The authors declare no conflicts of interest in this study.
Abbreviations
The following abbreviations are used in this manuscript:
| LD50 | Median lethal dose |
| VGSC | Voltage-gated sodium channel |
| RFLP | Restriction Fragment Length Polymorphism |
References
- Benito-Murcia, M.; Martín-Hernández, R.; Meana, A.; Botías, C.; Higes, M. Study of pyrethroid resistance mutations in populations of Varroa destructor across Spain. Res. Vet. Sci. 2022, 152, 34–37. [Google Scholar] [CrossRef] [PubMed]
- Van Der Steen, J.; Vejsnæs, F. Varroa control: A brief overview of available methods. Bee World 2021, 98, 50–56. [Google Scholar] [CrossRef]
- Dietemann, V.; Nazzi, F.; Martin, S.J.; Anderson, D.L.; Locke, B.; Delaplane, K.S.; Wauquiez, Q.; Tannahill, C.; Frey, E.; Ziegelmann, B. Standard methods for varroa research. J. Apic. Res. 2013, 52, 1–54. [Google Scholar] [CrossRef]
- Mitton, G.A.; Quintana, S.; Gimenez Martinez, P.; Mendoza, Y.; Ramallo, G.; Brasesco, C.; Villalba, A.; Eguaras, M.J.; Maggi, M.D.; Ruffinengo, S.R. First record of resistance to flumethrin in a varroa population from Uruguay. J. Apic. Res. 2016, 55, 422–427. [Google Scholar] [CrossRef]
- Gonzalez-Cabrera, J.; Davies, T.E.; Field, L.M.; Kennedy, P.J.; Williamson, M.S. An amino acid substitution (L925V) associated with resistance to pyrethroids in Varroa destructor. PLoS ONE 2013, 8, e82941. [Google Scholar] [CrossRef]
- Vlogiannitis, S.; Jonckheere, W.; Laget, D.; de Graaf, D.C.; Vontas, J.; Van Leeuwen, T. Pyrethroid target-site resistance mutations in populations of the honey bee parasite Varroa destructor (Acari: Varroidae) from Flanders, Belgium. Exp. Appl. Acarol. 2021, 85, 205–221. [Google Scholar] [CrossRef]
- Mitton, G.A.; Meroi Arcerito, F.; Cooley, H.; Fernandez de Landa, G.; Eguaras, M.J.; Ruffinengo, S.R.; Maggi, M.D. More than sixty years living with Varroa destructor: A review of acaricide resistance. Int. J. Pest Manag. 2022, 1–18. [Google Scholar] [CrossRef]
- Millán-Leiva, A.; Marín, Ó.; Christmon, K.; Vanengelsdorp, D.; González-Cabrera, J. Mutations associated with pyrethroid resistance in Varroa mite, a parasite of honey bees, are widespread across the United States. Pest Manag. Sci. 2021, 77, 3241–3249. [Google Scholar] [CrossRef]
- Morfin, N.; Rawn, D.; Petukhova, T.; Kozak, P.; Eccles, L.; Chaput, J.; Pasma, T.; Guzman-Novoa, E. Surveillance of synthetic acaricide efficacy against Varroa destructor in Ontario, Canada. Can. Entomol. 2022, 154, e17. [Google Scholar] [CrossRef]
- Hansen, G. Guide to Varroa Mite Controls for Commercial Beekeeping Operations. 2021. Available online: https://honeybeehealthcoalition.org/wp-content/uploads/2021/06/Commercial_Beekeeping_060621.pdf (accessed on 13 March 2025).
- McGruddy, R.A.; Bulgarella, M.; Felden, A.; Baty, J.W.; Haywood, J.; Stahlmann-Brown, P.; Lester, P.J. Are increasing honey bee colony losses attributed to Varroa destructor in New Zealand driven by miticide resistance? J. Apic. Res. 2024, 63, 648–659. [Google Scholar] [CrossRef]
- Maggi, M.D.; Ruffinengo, S.R.; Gende, L.B.; Eguaras, M.J.; Sardella, N.H. LC50 baseline levels of amitraz, coumaphos, fluvalinate and flumethrin in populations of Varroa destructor from Buenos Aires Province, Argentina. J. Apic. Res. 2008, 47, 292–295. [Google Scholar] [CrossRef]
- Goodwin, R.; Taylor, M.; McBrydie, H.; Cox, H. Base levels of resistance to common control compounds by a New Zealand population of Varroa destructor. N. Z. J. Crop Hortic. Sci. 2005, 33, 347–352. [Google Scholar] [CrossRef]
- Yarsan, E.; Yilmaz, F.; Sevin, S.; Akdeniz, G.; Celebi, B.; Ozturk, S.H.; Ayikol, S.N.; Karatas, U.; Ese, H.; Fidan, N. Investigation of resistance against to flumethrin using against Varroa destructor in Türkiye. Vet. Res. Commun. 2024, 48, 1683–1696. [Google Scholar] [CrossRef]
- Erdem, E.; Koç-İnak, N.; Rüstemoğlu, M.; İnak, E. Geographical distribution of pyrethroid resistance mutations in Varroa destructor across Türkiye and a European overview. Exp. Appl. Acarol. 2024, 92, 309–321. [Google Scholar] [CrossRef]
- Koç, N.; İnak, E.; Jonckheere, W.; Van Leeuwen, T. Genetic analysis and screening of pyrethroid resistance mutations in Varroa destructor populations from Turkey. Exp. Appl. Acarol. 2021, 84, 433–444. [Google Scholar] [CrossRef]
- Millán-Leiva, A.; Hernández-Rodríguez, C.S.; González-Cabrera, J. New PCR–RFLP diagnostics methodology for detecting Varroa destructor resistant to synthetic pyrethroids. J. Pest. Sci. 2018, 91, 937–941. [Google Scholar] [CrossRef]
- Stara, J.; Pekar, S.; Nesvorna, M.; Erban, T.; Vinsova, H.; Kopecky, J.; Doskocil, I.; Kamler, M.; Hubert, J. Detection of tau-fluvalinate resistance in the mite Varroa destructor based on the comparison of vial test and PCR–RFLP of kdr mutation in sodium channel gene. Exp. Appl. Acarol. 2019, 77, 161–171. [Google Scholar] [CrossRef]
- Mitton, G.A.; Quintana, S.; Mendoza, Y.; Eguaras, M.; Maggi, M.D.; Ruffinengo, S.R. L925V mutation in voltage-gated sodium channel of Varroa destructor populations from Argentina and Uruguay, with different degree of susceptibility to pyrethroids. Int. J. Acarol. 2021, 47, 374–380. [Google Scholar] [CrossRef]
- Wu, X.; Li, Z.; Yang, H.; He, X.; Yan, W.; Zeng, Z. The adverse impact on lifespan, immunity, and forage behavior of worker bees (Apis mellifera Linnaeus 1758) after exposure to flumethrin. Sci. Total Environ. 2023, 858, 160146. [Google Scholar] [CrossRef]
- Lodesani, M.; Colombo, M.; Spreafico, M. Ineffectiveness of Apistan® treatment against the mite Varroa jacobsoni Oud in several districts of Lombardy (Italy). Apidologie 1995, 26, 67–72. [Google Scholar] [CrossRef]
- Millán-Leiva, A.; Marín, Ó.; De la Rúa, P.; Muñoz, I.; Tsagkarakou, A.; Eversol, H.; Christmon, K.; VanEngelsdorp, D.; González-Cabrera, J. Mutations associated with pyrethroid resistance in the honey bee parasite Varroa destructor evolved as a series of parallel and sequential events. J. Pest Sci. 2021, 94, 1505–1517. [Google Scholar] [CrossRef]
- González-Cabrera, J.; Bumann, H.; Rodríguez-Vargas, S.; Kennedy, P.J.; Krieger, K.; Altreuther, G.; Hertel, A.; Hertlein, G.; Nauen, R.; Williamson, M.S. A single mutation is driving resistance to pyrethroids in European populations of the parasitic mite, Varroa destructor. J. Pest. Sci. 2018, 91, 1137–1144. [Google Scholar] [CrossRef]
- Farjamfar, M.; Saboori, A.; González-Cabrera, J.; Hernandez Rodriguez, C.S. Genetic variability and pyrethroid susceptibility of the parasitic honey bee mite Varroa destructor (Acari: Varroidae) in Iran. Exp. Appl. Acarol. 2018, 76, 139–148. [Google Scholar] [CrossRef]
- Almecija, G.; Schimmerling, M.; Del Cont, A.; Poirot, B.; Duquesne, V. Varroa destructor resistance to tau-fluvalinate: Relationship between in vitro phenotypic test and VGSC L925V mutation. Pest Manag. Sci. 2022, 78, 5097–5105. [Google Scholar] [CrossRef]
- Panini, M.; Reguzzi, M.C.; Chiesa, O.; Cominelli, F.; Lupi, D.; Moores, G.; Mazzoni, E. Pyrethroid resistance in Italian populations of the mite Varroa destructor: A focus on the Lombardy region. Bull. Insectol. 2019, 72, 227–232. [Google Scholar]
- Alissandrakis, E.; Ilias, A.; Tsagkarakou, A. Pyrethroid target site resistance in Greek populations of the honey bee parasite Varroa destructor (Acari: Varroidae). J. Apic. Res. 2017, 56, 625–630. [Google Scholar] [CrossRef]
- Bahreini, R.; González-Cabrera, J.; Hernández-Rodríguez, C.S.; Moreno-Martí, S.; Muirhead, S.; Labuschagne, R.B.; Rueppell, O. Arising amitraz and pyrethroids resistance mutations in the ectoparasitic Varroa destructor mite in Canada. Sci. Rep. 2025, 15, 1587. [Google Scholar] [CrossRef]
Disclaimer/Publisher’s Note: The statements, opinions and data contained in all publications are solely those of the individual author(s) and contributor(s) and not of MDPI and/or the editor(s). MDPI and/or the editor(s) disclaim responsibility for any injury to people or property resulting from any ideas, methods, instructions or products referred to in the content. |
© 2025 by the authors. Licensee MDPI, Basel, Switzerland. This article is an open access article distributed under the terms and conditions of the Creative Commons Attribution (CC BY) license (https://creativecommons.org/licenses/by/4.0/).